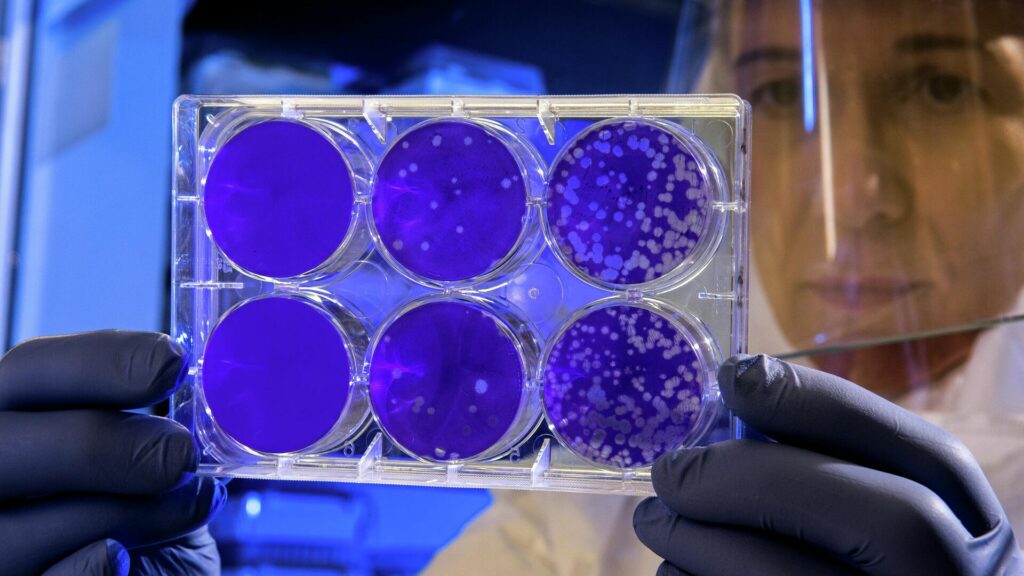

Existe la creencia de que los males como el cáncer o la diabetes no se transmiten de persona a persona. Sin embargo, un grupo de científicos alerta que los microbios que habitan nuestros cuerpos pueden ser el desencadenante de graves enfermedades. Lo peor de todo es que estos microorganismos se transmiten entre familiares, amigos y colegas.
Nuestro cuerpo está formado por unos 30 billones de células que conforman nuestro cuerpo, pero casi 40 billones más de células microbianas. La gran comunidad de bacterias, virus, protozoos y hongos presentes en el intestino, la boca, la piel y otros lugares se denomina microbioma.
En el pasado, los biólogos trataban de dividir los microbios en buenos y malos, es decir, patógenos. Ahora está cada vez más claro que esa división bipolar no es del todo cierta. La realidad es que todos los microorganismos que habitan en nuestros cuerpos forman una especie de ecosistema, de cuyo funcionamiento normal depende en gran medida nuestra salud.
Mientras que el genoma (la totalidad de todos los genes) se hereda de nuestros padres y permanece generalmente constante a lo largo de la vida, el microbioma, que también se establece al nacer, puede cambiar drásticamente y puede ser diferente a cada edad.
Su perfil personal está determinado por muchos factores: ecología, estilo de vida, composición de los alimentos y del agua. Además, influyen mucho las personas que nos rodean, sobre todo las que están en contacto permanente con nosotros: familia, amigos y compañeros.
¿Cómo evoluciona nuestro microbioma?
El primer estudio a gran escala que compara la composición de los microbiomas de distintas personas a nivel genético ha sido realizado por un grupo internacional de biólogos dirigido por Nicola Segata, de la Universidad de Trento (Italia). Participaron 18 institutos y centros de investigación de todo el mundo. Los autores analizaron más de 9.700 muestras de heces y saliva de personas procedentes de 20 países de los 5 continentes, que representaban a comunidades con estilos de vida muy diferentes.
Los resultados muestran que los genomas materno y neonatal presentan el mayor solapamiento, en torno al 50%. También los familiares comparten un porcentaje bastante alto de microbios comunes. Incluso personas del mismo pueblo presentan un elevado número de cepas comunes, mucho más que personas separadas por grandes distancias.
El intercambio de microbios se produce a través de todo tipo de contactos: la piel, las mucosas, las gotitas en el aire, los vapores y secreciones, y cualquier producto de la actividad vital. A pesar de ello, los científicos consideran que el factor más importante para la formación de un entorno bacteriano común es el tiempo que se pasa juntos.
La pandemia de COVID-19 demostró lo rápido que pueden transmitirse los gérmenes de una persona a otra en las sociedades modernas. Y los buenos se propagan a la misma velocidad que los malos. Por eso, cada vez más, los científicos aplican el término “contagioso” no solo a los patógenos, sino también al microbioma en su conjunto.
Hace unos años, un grupo internacional de biólogos dirigido por Amar Sarkar, de la Universidad de Cambridge, introdujo por primera vez el concepto de microbioma social: una única megacomunidad microbiana que coloniza un gran grupo de personas unidas por lazos sociales.
Los autores proponen considerarlo como una especie de archipiélago, donde cada persona es una isla habitada por un conjunto especial de microorganismos. Poco a poco se van extendiendo por el archipiélago, igual que los pájaros o los insectos se extienden por las islas.
¿Puede un microbioma común provocar enfermedades comunes?
En un nuevo artículo publicado en la revista Cell, los investigadores analizan el impacto del microbioma social en la salud humana. Observan que el intercambio microbiano desempeña un papel importante en la susceptibilidad y resistencia de las personas a enfermedades infecciosas y no infecciosas.
La aparición de microbios extraños puede provocar reacciones alérgicas, reestructurar el metabolismo y el sistema inmunitario del organismo, reducir la eficacia de los medicamentos e incluso desencadenar enfermedades graves como la diabetes o el cáncer. Se conocen casos en los que personas que viven en la misma familia se han infectado mutuamente por bacterias resistentes a los antibióticos, si una de ellas fue sometida a un tratamiento prolongado con antibióticos.
Además, los cambios en la composición de la microflora intestinal afectan significativamente a la resistencia del organismo a los patógenos o a las condiciones ambientales desfavorables.
“Algunas enfermedades no transmisibles pueden tener en realidad un aspecto infeccioso. Sin embargo, esta idea podría ser preocupante. Los microbios que se transmiten socialmente también pueden ayudar a proteger contra las enfermedades”, afirma en el comunicado de prensa Rachel Carmody, una de las autoras del estudio y profesora adjunta de biología evolutiva humana en la Universidad de Harvard.
Hasta el momento, los investigadores solo han analizado los microbiomas de personas sanas. Ahora se embarcan en la siguiente fase: averiguar el papel del metabolismo microbiano en el desarrollo de determinadas enfermedades. Por ejemplo:
Ciertas cepas de E. coli pueden producir toxinas que aumentan el riesgo de cáncer.
Las personas con presencia de la bacteria Fusobacterium tienen peor pronóstico de cáncer colorrectal.
Los microbios intestinales que afectan a los niveles de glucosa e insulina en el organismo se han relacionado con la obesidad y afecciones como el síndrome metabólico e incluso la diabetes de tipo 2.
Se considera también que los desequilibrios en el microbioma están relacionados con la neurodegeneración y pueden desencadenar el desarrollo de la enfermedad de alzhéimer.
“Si todas estas enfermedades dependen, al menos en parte, de los microbios, y el microbioma es, al menos en parte, contagioso, entonces estas enfermedades también deberían reconocerse como parcialmente contagiosas”, concluye Nicola Segata.